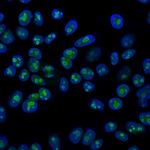
Nucleolin (Marker of Human Cells) Antibody in Immunocytochemistry (ICC/IF)

Search
NeoBiotechnologies
Nucleolin (Marker of Human Cells) Monoclonal Antibody (364-5)
{{$productOrderCtrl.translations['antibody.pdp.commerceCard.promotion.promotions']}}
{{$productOrderCtrl.translations['antibody.pdp.commerceCard.promotion.viewpromo']}}
{{$productOrderCtrl.translations['antibody.pdp.commerceCard.promotion.promocode']}}: {{promo.promoCode}} {{promo.promoTitle}} {{promo.promoDescription}}. {{$productOrderCtrl.translations['antibody.pdp.commerceCard.promotion.learnmore']}}
产品信息
4691-MSM2-P1ABX
种属反应
宿主/亚型
分类
类型
克隆号
抗原
偶联物
形式
浓度
规格
纯化类型
保存液
内含物
保存条件
运输条件
产品详细信息
Does not react with Mouse, Rat or Cow
靶标信息
Nucleolin (NCL), a eukaryotic nucleolar phosphoprotein, is involved in the synthesis and maturation of ribosomes. It is located mainly in dense fibrillar regions of the nucleolus. Human NCL gene consists of 14 exons with 13 introns and spans approximately 11kb. The intron 11 of the NCL gene encodes a small nucleolar RNA, termed U20.
仅用于科研。不用于诊断过程。未经明确授权不得转售。
篇参考文献 (0)
生物信息学
蛋白别名: FLJ45706; FLJ59041; nucl antibody; Nucleolin; Protein C23; unnamed protein product
基因别名: C23; NCL; Nsr1
UniProt ID: (Human) P19338
Entrez Gene ID: (Human) 4691